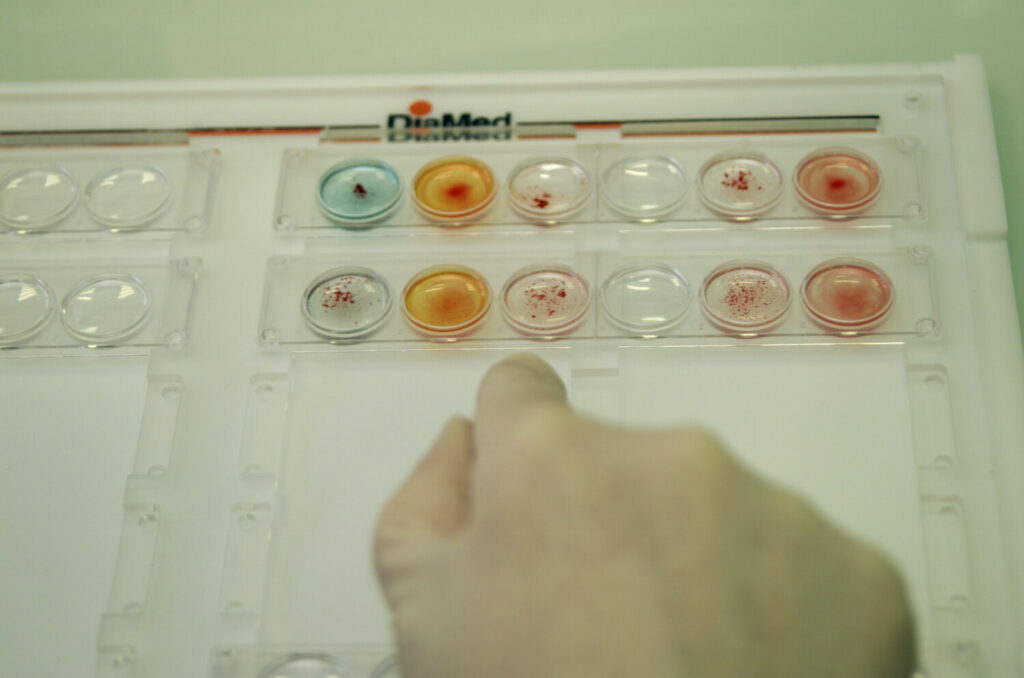

AJPHOTOS /EAST NEWS
由华沙大学化学学院的 Barbara Kowalewska 博士领导的华沙大学科学家团队开发了一种具有高稳定性的石墨烯基质,可将其用于医学。
该矩阵将用作生物传感器设计的关键元素,该设计以非侵入性方式监测或诊断后天性疾病和慢性疾病。
华沙大学的科学家在基质中使用石墨烯,可以有效传输医学生物传感器获得的患者健康数据。
矩阵生产技术已获得专利。华沙大学和 Biometryks LLC 签订了使用许可协议。石墨烯基质将用于构建 Biometryks 生物传感器,该传感器可无创地分析汗液、尿液或血液样本,监测和诊断疾病。







